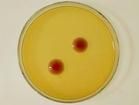
高聚物非晶態結構

基本信息
高聚物非晶態結構
高聚物非晶態結構高聚物的非晶態包括完全不能結晶的高聚物本體、部分結晶高聚物的非晶區和結晶高聚物熔體經驟冷而凍結的非晶態固體。從結構概念來看,高聚物非晶態與小分子非晶態相同,即對高分子鏈的結構單元(相當於一個單體)來說,只有近程有序而缺乏長程有序。但是高分子鏈是由很大數目的鏈結構單元通過共價鍵連線起來的,從分子鏈尺寸的角度來看,高聚物非晶態又有它獨特的形態結構問題。
無規線團
20世紀70年代以來通過許多實驗(特別是中子小角散射實驗)的驗證,證明完全不能結晶的高聚物本體和高聚物熔體中高分子鏈的形態符合P.J.弗洛里在50年代從理論上推斷的無規線團(即高斯線團)形態,而且線團尺寸(如均方半徑)與從θ-溶劑稀溶液中測定的尺寸相同(見高分子溶液)。結晶高聚物熔體經驟冷而凍結的非晶態,就是熔體中高分子鏈形態的凍結,其結構也呈無規線團。從非晶態高聚物固體的密度數據,可以計算出這樣一個無規線團尺寸的空間存在著幾十個同樣的無規線團的質量中心,這些無規線團在空間相互穿透地堆砌在一起,構成高聚物非晶態的分子鏈凝聚態結構。所以高聚物非晶態結構是相互穿透的無規線團的密集堆砌。但不能排除在分子鏈的局部小尺寸區域會出現按分子鏈方向有許多條分子鏈平行堆砌的可能性,構成非結晶性高聚物分子鏈間的纏結點、分子鏈局部堆砌的近程有序或結晶性高聚物結晶時的核原等。50年代中期以來,曾有人提出在非晶態高聚物中存在相互平行的鏈束結構和尺寸為50~100埃的微球結構,但迄今尚缺乏可信實驗證據。
無序過渡區
部分結晶的高聚物中在結晶度不大時存在片晶聚集體,如片晶之間的非晶態部分(見圖) 和球晶之間的非晶態部分,前者包括高分子鏈從一個片晶(片晶厚度僅 100埃,片晶與片晶間的距離相近)伸入另一個片晶之間的無序過渡區,高分子鏈從片晶的有序區出來通過鏈的摺疊再進入同一個片晶以前的無序過渡區以及從片晶端面伸出的分子鏈的末端等;後者則與完全不能結晶的高聚物非晶態結構相同。片晶間的非晶態部分的高分子鏈的形態當然與球晶間的非晶態部分不同,它的鏈段運動受片晶有序區的牽制,這在與鏈段運動有關的實驗(如動態力學性能溫度譜)中可以得到反映。
和球晶之間的非晶態部分,前者包括高分子鏈從一個片晶(片晶厚度僅 100埃,片晶與片晶間的距離相近)伸入另一個片晶之間的無序過渡區,高分子鏈從片晶的有序區出來通過鏈的摺疊再進入同一個片晶以前的無序過渡區以及從片晶端面伸出的分子鏈的末端等;後者則與完全不能結晶的高聚物非晶態結構相同。片晶間的非晶態部分的高分子鏈的形態當然與球晶間的非晶態部分不同,它的鏈段運動受片晶有序區的牽制,這在與鏈段運動有關的實驗(如動態力學性能溫度譜)中可以得到反映。

